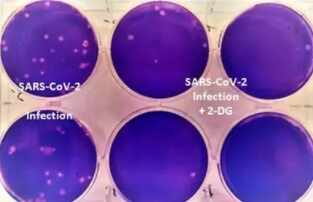

நீரில் கலந்து குடிக்கும் கொரோனா எதிர்ப்பு மருந்து அறிமுகம்.. விரைவில் குணமாகலாம் !
நீரில் கலந்து குடிக்கும் கொரோனா எதிர்ப்பு மருந்து அறிமுகம்.. விரைவில் குணமாகலாம் !

டி-டியோக்ஸி டி-குளுகோஸ் (2-டிஜி) என்ற கொரோனா தடுப்பு மருந்தை இந்திய பாதுகாப்பு ஆராய்ச்சி மற்றும் வளர்ச்சி அமைப்பின் (டிஆர்டிஓ) ஆய்வகமான இன்ஸ்ட்டியூட் ஆஃப் நியூக்ளியர் மெடிசன் அண்ட் அலைட் சயின்ஸ் (ஐஎன்எம்ஏஎஸ்) மற்றும் டாக்டர் ரெட்டிஸ் மருந்து நிறுவனத்துடன் இணைந்து தயாரித்துள்ளது.
இந்தியாவில் கொரோனா பாதிப்பு கடந்த நாட்களை விட தற்போது சிறிது சிறிதாக குறைந்து வருகிறது. எனினும் ஒருநாள் பாதிப்பு சுமார் 3 லட்சம் என்ற அளவிலேயே நிலவுகிறது. அதனை கட்டுப்படுத்த மத்திய அரசு பல்வேறு நடவடிக்கைகளை எடுத்து வருகிறது.

இந்நிலையில், கொரோனா சிகிச்சைக்கு உதவும் டி-டியோக்ஸி டி-குளுகோஸ் (2-டிஜி) மருத்தை மத்திய சுகாதாரத்துறை அமைச்சர் ஹர்ஷ்வர்தன் மற்றும் மத்திய பாதுகாப்புத்துறை அமைச்சர் ராஜ்நாத் சிங் ஆகியோர் இன்று வெளியிட்டனர். முதல்கட்டமாக 10,000 டி-டியோக்ஸி டி-குளுகோஸ் மருந்து பாக்கெட்டுகள் டெல்லியில் உள்ள மருத்துவமனைக்கு விநியோகம் செய்யப்பட்டுள்ளது.
டி-டியோக்ஸி டி-குளுகோஸ் (2-டிஜி) விவரம்:
சென்டர் ஃபார் செல்லுலார் அண்ட் மாலிகுலர் பயாலாஜி (சிசிஎம்பி) உதவியுடன் டிஆர்டிஓ மற்றும் ஐஎன்எம்ஏஎஸ் அமைப்பினர் கடந்த ஆண்டு ஆய்வில் இறங்கினர். இந்த ஆய்வில் டி-டியோக்ஸி டி-குளுகோஸ் (2-டிஜி) மருந்தின் மூலக்கூறுகள் கொரோனா வைரசுக்கு எதிராக சிறப்பாக செயல்படுவது தெரியவந்தது.
இந்த முடிவுகளின் அடிப்படையில் டி-டியோக்ஸி டி-குளுகோஸ் (2-டிஜி) மருத்தை கிளினிக்கல் பரிசோதனை நடத்த அனுமதி அளிக்கப்பட்டது. இதைத் தொடர்ந்து டாக்டர் ரெட்டீஸ் நிறுவனம், டிஆர்டிஓ ஆகியவை இணைந்து கிளினிக்கல் பரிசோதனையை 3 கட்டங்களாக கொரோனா நோயாளிகளிடம் நடத்தின. பவுடர் வடிவிலான இந்த மருந்தை தண்ணீர் கலந்து குடிக்க முடியும்.
இந்த மருந்து உடலில் சென்று வைரஸால் பாதிக்கப்பட்ட செல்களை அடையாளம் கண்டுபிடித்து ஒருங்கிணைத்து, புதிதாக எந்த செல்களும் பாதிக்கப்படாமல் தடுத்து, வைரஸ் வளர்ச்சியையும் தடுக்கிறது என்பது தெரியவந்துள்ளது. மேலும், கொரோனாவால் பாதிக்கப்பட்டு சிகிச்சை பெற்று வருபவர்கள் இந்த மருத்தை எடுக்கும் போது மருத்துவமனையில் சிகிச்சை பெறும் நாட்கள் வெகுவாக குறைந்து விரைவில் குணமடைவது தெரியவந்துள்ளது. இந்த மருத்துக்கு அவசரகால பயன்பாட்டிற்கு கொண்டு வர இந்திய மருத்து தர கட்டுப்பாட்டு அமைப்பு அனுமதி வழங்கியுள்ளது.
newstm.in

